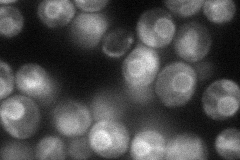
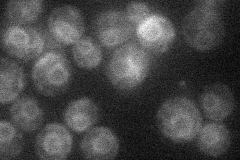

View description
Subunit of the mitochondrial F1F0 ATP synthase, which is a large enzyme complex required for ATP synthesis; termed subunit I or subunit j; does not correspond to known ATP synthase subunits in other organisms
Localization:
Intensity:
Fold change:
Significance:
-
C’ GFP library in SD

mitochondria74.88 -
N' NOP1pr-GFP in SD
ER59.8996 -
N' TEF2pr-mCherry in SD
ER17.8187 -
N' NATIVEpr-GFP in SD

below threshold25.3388 -
N' TEF2pr-VC and Cyto-VN in SD

below threshold21.8985 -
C’ GFP library in SD+DTT

mitochondria74.090.98No -
C’ GFP library in SD+H2O2

mitochondria54.820.73No -
C’ GFP library in Starvation Media

mitochondria77.471.03No -
C’ GFP library on the background of Pup2-DaMP

mitochondria -
C’ GFP library on the background of CCT mutant

mitochondria61.07460.815584No
